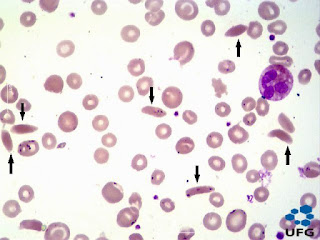

·
Forma: Hoz o
de banano
·
Descripción
del núcleo y citoplasma: Núcleo ausente con citoplasma acidófilo
y morfología variable.
·
Organelas
y/o inclusiones evidentes en la misma: Membrana
citoplasmática con morfología alargada o de banano.
·
Sitio
del cuerpo donde se pueden encontrar en patologías: Sangre
periférica
·
Patologías
asociadas:
Anemia falciforme, hemoglobinopatía S
(Ross y Pawlina, 2007)
Imagen recuperada de: https://hematologia.farmacia.ufg.br/p/7041-drepanocitos
No hay comentarios:
Publicar un comentario